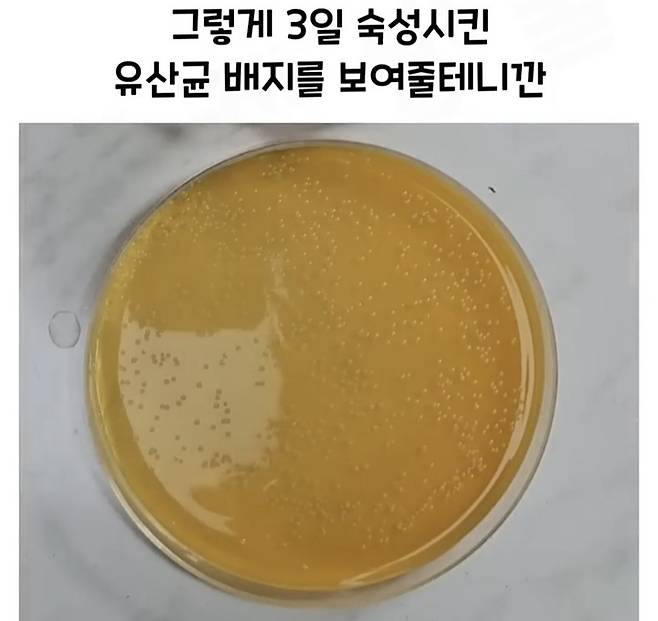
Screenshot_20241218_183100_Video Player.jpg 요구르트 유산균 수를 세는 방법.jpg
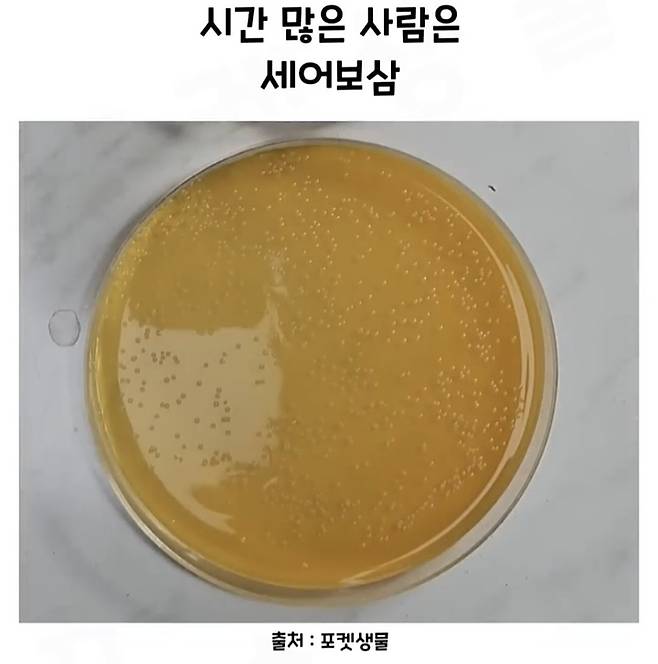
Screenshot_20241218_183106_Video Player.jpg 요구르트 유산균 수를 세는 방법.jpg

Screenshot_20241218_182849_Video Player.jpg 요구르트 유산균 수를 세는 방법.jpg

Screenshot_20241218_182854_Video Player.jpg 요구르트 유산균 수를 세는 방법.jpg

Screenshot_20241218_182900_Video Player.jpg 요구르트 유산균 수를 세는 방법.jpg

Screenshot_20241218_182905_Video Player.jpg 요구르트 유산균 수를 세는 방법.jpg

Screenshot_20241218_182913_Video Player.jpg 요구르트 유산균 수를 세는 방법.jpg

Screenshot_20241218_182919_Video Player.jpg 요구르트 유산균 수를 세는 방법.jpg

Screenshot_20241218_182925_Video Player.jpg 요구르트 유산균 수를 세는 방법.jpg

Screenshot_20241218_182931_Video Player.jpg 요구르트 유산균 수를 세는 방법.jpg

Screenshot_20241218_182937_Video Player.jpg 요구르트 유산균 수를 세는 방법.jpg

Screenshot_20241218_182944_Video Player.jpg 요구르트 유산균 수를 세는 방법.jpg

Screenshot_20241218_182953_Video Player.jpg 요구르트 유산균 수를 세는 방법.jpg

Screenshot_20241218_183000_Video Player.jpg 요구르트 유산균 수를 세는 방법.jpg

Screenshot_20241218_183011_Video Player.jpg 요구르트 유산균 수를 세는 방법.jpg

Screenshot_20241218_183015_Video Player.jpg 요구르트 유산균 수를 세는 방법.jpg

Screenshot_20241218_183027_Video Player.jpg 요구르트 유산균 수를 세는 방법.jpg

Screenshot_20241218_183034_Video Player.jpg 요구르트 유산균 수를 세는 방법.jpg

Screenshot_20241218_183042_Video Player.jpg 요구르트 유산균 수를 세는 방법.jpg

Screenshot_20241218_183048_Video Player.jpg 요구르트 유산균 수를 세는 방법.jpg

Screenshot_20241218_183054_Video Player.jpg 요구르트 유산균 수를 세는 방법.jpg

Screenshot_20241218_183100_Video Player.jpg 요구르트 유산균 수를 세는 방법.jpg

Screenshot_20241218_183106_Video Player.jpg 요구르트 유산균 수를 세는 방법.jpg